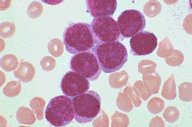

Description
Bone smear from a patient with acute
monoblastic leukemia, M5A. The blasts have a
moderate amount of cytoplasm and somewhat
coarse nuclei. The nucleoli are not unusually
prominent. The blasts were positive with the
nonspecific esterase stain and the patient had an
associated T(9;11) chromosome abnormality.
|
|
Click on this image
to enlarge it, then
on Back botton
in the Netscape Menu
to shrink it back down



|